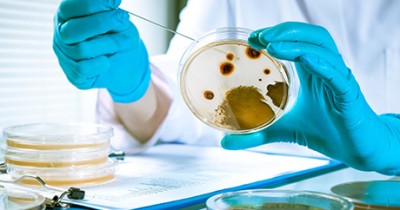
Analyse de moisissures

Échantillonnage en Environnement
Les activités d’échantillonnage dans l’industrie environnementale sont essentielles pour la santé et la sécurité de la population. Ces activités requièrent des outils d’analyse fiables pour le contrôle de la contamination de l’air, de l’eau et des sols par des polluants, des substances toxiques et des matières dangereuses, ainsi que pour l'assainissement de bâtiments, de sites miniers ou d'eaux souterraines contaminées.

Analyse de terrains contaminés
Des analyses de sol sont nécessaires pour déterminer si un terrain est contaminé par des polluants, des hydrocarbures ou des matières dangereuses pouvant représenter un réel danger pour les écosystèmes. Des analyses fréquentes doivent ainsi être pratiquées afin d’éviter tout type de contamination.

Contrôle de la qualité des eaux souterraines
De telles analyses peuvent être requises pour s'assurer que les activités d'une entreprise n'entraînent pas de contamination des eaux environnantes, par le rejet de matières dangeureuses, par exemple.

Analyse du microbiome des sols
Le microbiome des sols joue un rôle majeur dans le maintien de la santé des sols et contribue à la structuration des sols. L’analyse du microbiome permet d’identifier et de quantifier des indicateurs biologiques. Ces derniers, combinés à des indicateurs physiques et chimiques, peuvent être utilisés par des modèles prévisionnels pour définir des indices de productivité du sol, de risque de maladies et d’efficacité de séquestration du carbone.
Applications
Des outils d'échantillonnage fiables et sécuritaires sont essentiels afin d'effectuer les divers tests et analyses requis au sein de cette industrie.
-

Détection de mazout dans le sol
Des déversements accidentels de mazout peuvent survenir, lors du remplissage du réservoir d'huile à chauffage, par exemple. Dans un tel cas, des analyses de sol dans un périmètre apparemment affecté permettront de connaître le niveau de concentration du contaminant et son étendue afin d'entreprendre les mesures nécessaires pour en disposer adéquatement.
-

Échantillonnage de matières résiduelles fertilisantes (MRF)
Les MRF sont issues des résidus industriels ou municipaux et font l'objet d'un protocole d'échantillonnage très strict. Des outils d'analyse stériles sont requis pour faire l'analyse des paramètres microbiologiques de ces échantillons.
-
Analyse de moisissures
De nombreux contaminants présents dans l'air peuvent avoir des effets néfastes sur la santé humaine, mais aussi animale et des plantes. Il est donc primordial de mettre en place des stratégies d'échantillonnage des contaminants provenant de sources naturelles ou de sources anthropiques se retrouvant dans l'air et sur divers matériaux et surfaces afin de déterminer le ou les éléments à risque et leur niveau de toxicité.
L'avantage LABPLAS
Faire affaire avec LABPLAS vous assure des produits de qualité et un service adapté à vos besoins.

Gamme de produits biodégradables – Parce que c’est important pour nous
LABPLAS ouvre la voie en offrant une solution simple et efficace aux défis environnementaux d’aujourd’hui. Sans compromis sur la fiabilité, notre plastique biodégradable ne sacrifie jamais aucune norme et répond aux exigences les plus élevées de l’industrie.

Adaptabilité et flexibilité
Chez LABPLAS, nous comprenons l’importance pour nos clients de disposer d’outils adaptés à leur industrie et à leurs besoins. Nos équipes de vente, de service à la clientèle et de recherche et développement sont toujours disponibles pour vous aider dans vos recherches et pour répondre à vos questions.

Sacs étanches et hermétiques
Nos sacs d’échantillonnage stériles sont étanches et hermétique afin de vous assurer le plus haut niveau de sécurité sur le marché. Ils sont robustes et conçus pour résister à tout type de manipulation ainsi qu’aux homogénéisateurs. Vos opérations se dérouleront en toute quiétude!













































